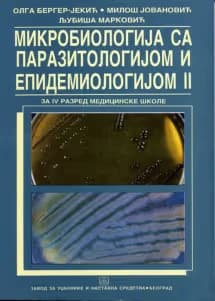
Mikrobiologija sa parazitologijom i epidemiologijom 2 za četvrti razred

Srednja Škola
Pronađeno 141 udžbenika

Kancelarijsko poslovanje 4 – udžbenik za četvrti razred
Bosiljka Mijatović, Nevenka Subotić-Konstantinović

Carinski sistem i carinski postupak 4 – udžbenik za četvrti razred
Tomislav Todorović

Akušerstvo sa negom 2 za četvrti razred
Dragomir Mladenović, Aleksandra Mihailović, Zorica Bogdanović

Epidemiologija 2 za četvrti razred
Zoran Radovanović, Slavenka Janković, Zorica Šeguljev, Ivana Jevremović, Katarina Bukomirović

Zdravstvena nega 4 za četvrti razred
Sanja Mažić, Milan Terzić, Mirjana Alimpić, Biljana Putniković, Slavka Marković

Ginekologija sa negom 4 za četvrti razred
Dragomir Mladenović, Aleksandra Mihailović, Zorica Bogdanović

Mikrobiologija sa parazitologijom i epidemiologijom 2 za četvrti razred
Ljubiša Marković, Olga Berger-Jekić, Miloš Jovanović

Interne bolesti sa negom 2 za četvrti razred
Jovanka Kapor-Drezgić, Jovan Teodorović, Stanko Ćorić, Stevan Plješa, Olga Jovanović, Lidija Burg, Zorica Rašić, Gradimir Golubović

Parcijalna proteza 4 za četvrti razred
Ljiljana Tihaček-Šojić, Vladimir Jovanović, Aleksandar Milošević, Dragić Jovanović

Kancelarijsko poslovanje 4 – udžbenik za četvrti razred
Bosiljka Mijatović, Nevenka Subotić-Konstantinović

Carinski sistem i carinski postupak 4 – udžbenik za četvrti razred
Tomislav Todorović

Akušerstvo sa negom 2 za četvrti razred
Dragomir Mladenović, Aleksandra Mihailović, Zorica Bogdanović

Epidemiologija 2 za četvrti razred
Zoran Radovanović, Slavenka Janković, Zorica Šeguljev, Ivana Jevremović, Katarina Bukomirović

Zdravstvena nega 4 za četvrti razred
Sanja Mažić, Milan Terzić, Mirjana Alimpić, Biljana Putniković, Slavka Marković

Ginekologija sa negom 4 za četvrti razred
Dragomir Mladenović, Aleksandra Mihailović, Zorica Bogdanović

Mikrobiologija sa parazitologijom i epidemiologijom 2 za četvrti razred
Ljubiša Marković, Olga Berger-Jekić, Miloš Jovanović

Interne bolesti sa negom 2 za četvrti razred
Jovanka Kapor-Drezgić, Jovan Teodorović, Stanko Ćorić, Stevan Plješa, Olga Jovanović, Lidija Burg, Zorica Rašić, Gradimir Golubović

Parcijalna proteza 4 za četvrti razred
Ljiljana Tihaček-Šojić, Vladimir Jovanović, Aleksandar Milošević, Dragić Jovanović